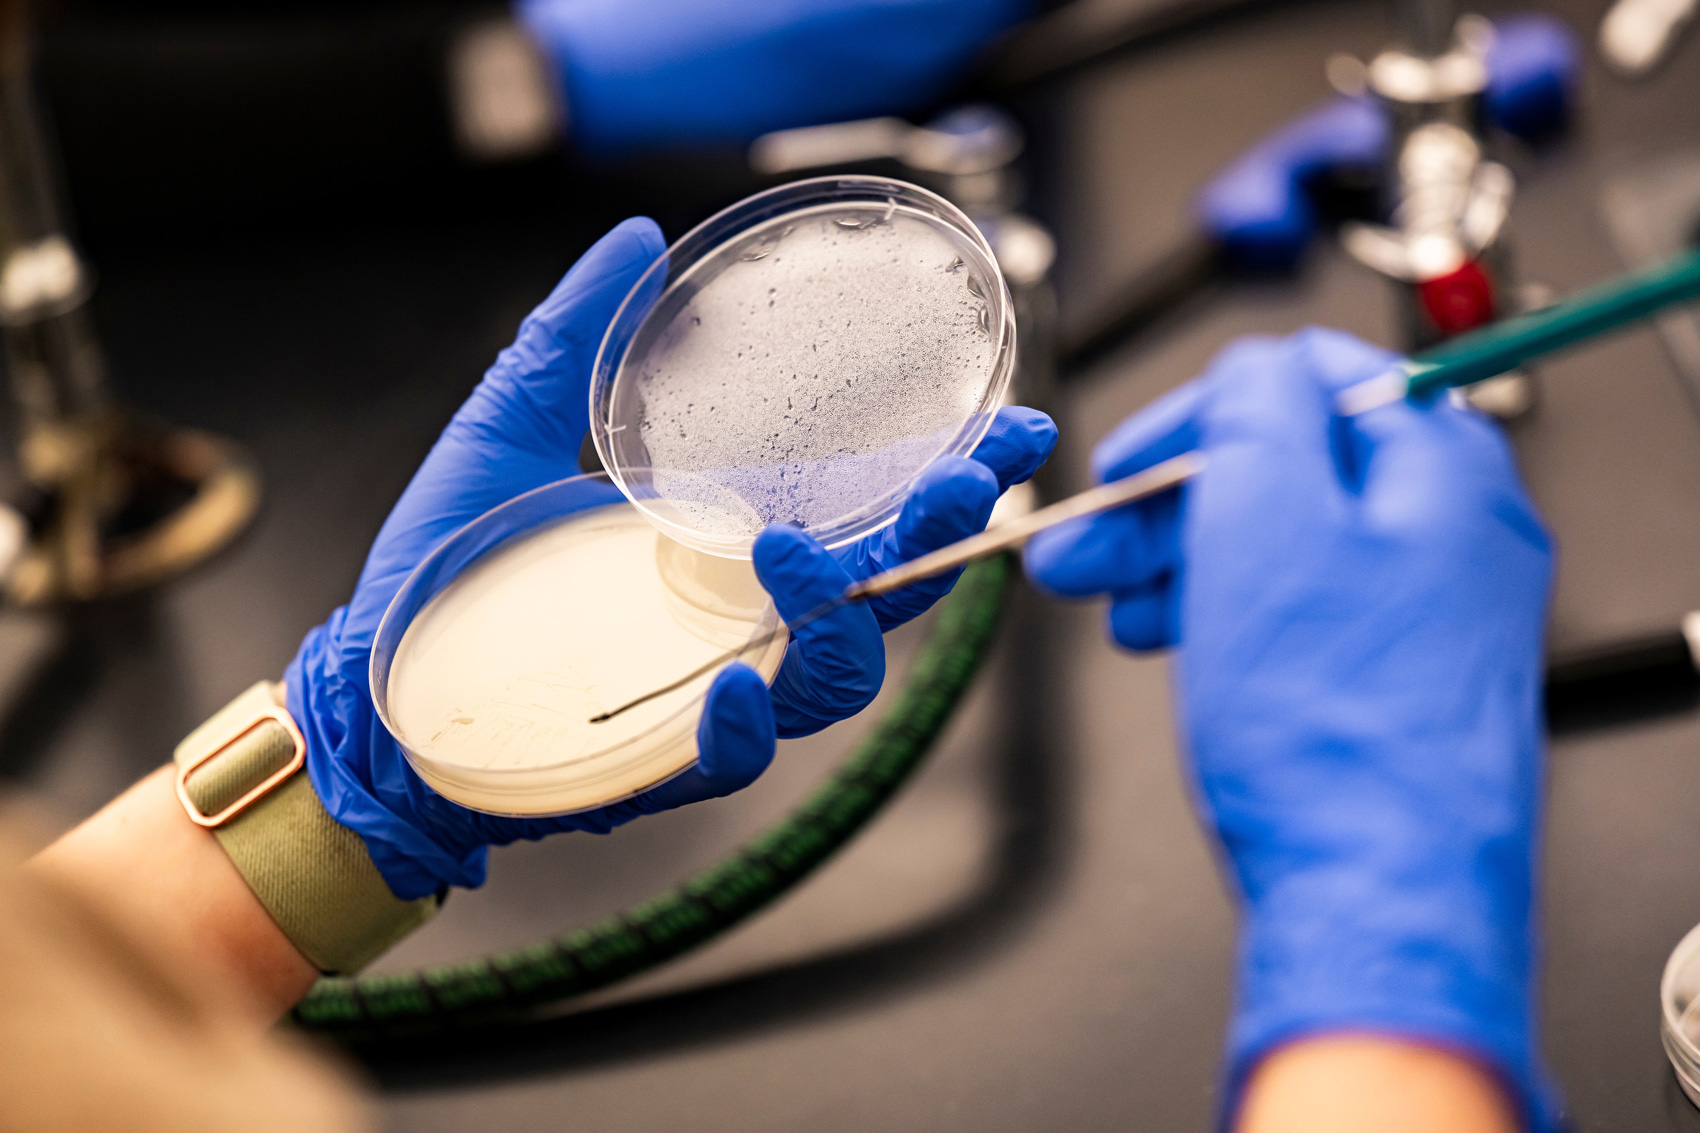

At a lab table inside San Jacinto College’s Central Campus in mid-January, Sam Rayburn High School senior Abigail Gova wields a BIC lighter to ignite her Bunsen burner. Once ablaze, her lab partner, Paola Alvarado, gingerly passes the tip of a metal wire through the blue flame.
The Pasadena ISD students are practicing sterilization of lab tools by simulating aseptic techniques, a vital skill for preventing contamination with bacteria. It’s an early lesson in one of their final courses they need to complete before earning a health sciences associate degree, fast-tracking their path into the medical field.
“Because of how much I’ve loved this,” said Alvarado, gesturing around the lab, “I want to be a nurse. I want to go into pediatric nursing and be with kids.”
By earning their degrees from SJC before graduating from high school, the pair will join the hundreds of Pasadena students benefiting from the district’s Early College partnership, one of the state’s most successful dual credit programs created primarily for lower-income, first-generation college students. Over the past few years, roughly 1-in-12 graduates from the southeast Houston district have left with an associate degree, a rate that dwarfs other Houston-area districts and ranks near the top among Texas’ largest districts.
For families in Pasadena, where four of every five students are considered low-income, the dual credit program provides a chance for students to take high school and college classes at the same time for free.
Graduates can save thousands of dollars on college tuition and fees, while opening opportunities for higher-paying jobs. Most graduates ultimately attend four-year universities and pursue a bachelor’s degree, an experience made less daunting by the rigorous college-level courses they took in high school.
Pasadena’s success stems, in large part, from its districtwide commitment to the program and close partnership with SJC, which agrees to share faculty, facilities and resources with the district.
Unlike many districts that offer limited dual credit programs, each of Pasadena’s five open-enrollment high schools uses the Early College model, making it available to hundreds of students annually. The program spans four years, with students starting college classes as freshmen. Students must take mandatory courses on college readiness skills. And college professors, rather than high school teachers, deliver most of the instruction.
“They’re being taught how to be a college student, and so by the time they’re done, and they actually go to their four-year university, they have these skills down pat,” said Arturo Del Barrio, Pasadena’s communications director.
That’s the case for Alvarado, a Sam Rayburn High senior. She plans to apply to several universities, including the University of Houston and Houston Christian University, but has her fingers crossed for an acceptance to UTHealth.
“(This degree) means that I’ll be ahead, and get to do what I want to do for work, faster,” Alvarado said. “It will save a lot of time and money. This will basically take two years off my schooling.”

Setting the expectation
Many school districts in Texas offer avenues for high school students to obtain college credit, helping nearly a quarter of graduates to earn some credit. But only 2.5 percent of the Class of 2023 completed an associate degree, state data show.
Pasadena and SJC began their dual credit partnership 14 years ago, with a small class at Pasadena High School. The initiative expanded in the late 2010s, when Pasadena became the first large Houston district to implement Early College programs at all of its neighborhood high schools. About 135 freshmen now enroll yearly at each campus.
When students enroll in SJC and Pasadena’s program, it’s clear that they’re expected to complete their associate degree, Deputy Chancellor Laurel Williamson said.
Most Pasadena students opt for general studies, health sciences or business focuses. About 180 students apply each year, McCarley said, so district officials use a lottery system that gives preference to students considered economically disadvantaged by the state, rather than hinging admission on academic achievement. Students don’t have to pay for tuition, books and other costs, which the Texas Higher Education Coordinating Board’s FAST program helps fund.
“This is not a four-year college where they’ve been groomed to go to college their whole life. … It’s a different student here,” said SJC professor Robin Wright, who teaches the college’s microbiology lab. “The population of students … they’re someone that may not have ever had the opportunity to go to college.”
‘A really good support system’
Pasadena students begin taking college classes at the start of their freshman year, meaning they simultaneously adjust to high school and college. The transition requires guidance, college and district officials say.
District and college staff start recruiting and preparing students while they’re still in middle school. College deans and counseling staff visit schools during lunch periods to talk about Early College. Campus leaders host “parent nights” to spread the word. The district sends information packets to the homes of all eighth graders in the district.
“Generally, students (in other districts) don’t start dual credits until junior year,” McCarley said. “We have support in place from the time the kids enter … to get them acclimated to the fact that they’re going to be 14 years old, and we’re going to be expecting them to be college-ready.”


From the beginning, Pasadena and SJC staff “teach them how to become college students,” Williamson said. Incoming students complete a free “Bridge” summer program, which establishes high school academic and behavioral expectations and helps prepare them for state and national college entrance exams, like the Texas Success Initiative Assessment. In the fall, freshmen begin “dipping their toes” in with several less demanding college courses, such as music appreciation or sociology.
Students then layer on an increasing number of college courses, with juniors and seniors eventually learning alongside college-age students in SJC classrooms.
Students also must take an “AVID” course every year, which aims to prepare students for college by teaching skills like time management, note-taking or sending proper emails to professors. Students can also participate in any extracurriculars at SJC, like the college’s athletic teams.
“I think the biggest thing is that I feel like I have a really good support system,” said Gova, the Sam Rayburn High senior. “All of the teachers, all of the students, instructors, everyone, they are willing to help if you’re going through a road bump. They’re always gonna help you out and be there for you.”
‘We celebrate each other’
Toward the end of Wright’s class, students practiced streaking milk agar in petri dishes, which isolates bacteria for examination. Wright, however, noticed something was amiss at the lab’s center table: their streaks were too heavy-handed, slicing into the jello-like agar. The slip-up sparked a teaching moment.
“We’re gonna mess up, OK? Just get over it,” Wright told the room. “We are here to learn. That’s what college is, right? I’m here to teach you. So don’t ever feel afraid. As a group, we celebrate each other, we don’t make each other feel bad.”

Much of the program’s success, SJC and Pasadena leaders say, is thanks to teachers like Wright. SJC professors deliver most instruction across the Early College, traveling to Pasadena schools to teach freshmen and sophomores and hosting juniors and seniors in the college’s classrooms. Many other districts rely more on high school teachers credentialed to provide college-level dual credit instruction.
Because of the approach by SJC and Pasadena, the partnership is at its current capacity of students, with no immediate plans to expand. SJC professors also teach more students through smaller-scale partnerships with Deer Park, Galena Park, Sheldon and Clear Creek ISDs.
“You might find that (other colleges) … really lean more heavily on those high school teachers to deliver the instruction. I think one of the reasons that our ISDs like this (partnership) is because, for the most part, it’s our faculty,” Williamson said.
Wright has come to prefer teaching the dual credit students, telling the program’s director, “‘Send them to me.’” She’s warmed by the interactions between high schoolers and older students.
“When some of the (high school) students are not paying attention, (adult students) say, ‘Hey, she’s right. You’ve got to pay attention. I wish they would’ve had dual credit when I was in high school,’” Wright said. “Then they start sitting up in the seat, like, ‘Oh yeah, I got a good opportunity here.’”
Miranda Dunlap covers Houston’s community colleges in partnership with Open Campus. Despite roughly half of Houston’s higher-education students attending community colleges, there hasn’t been much news covering these systems or students — until now. Her reporting holds institutions accountable, highlights barriers faced by students and helps them navigate their opportunities. Reach Miranda at miranda@houstonlanding.org or on Twitter and Instagram.
